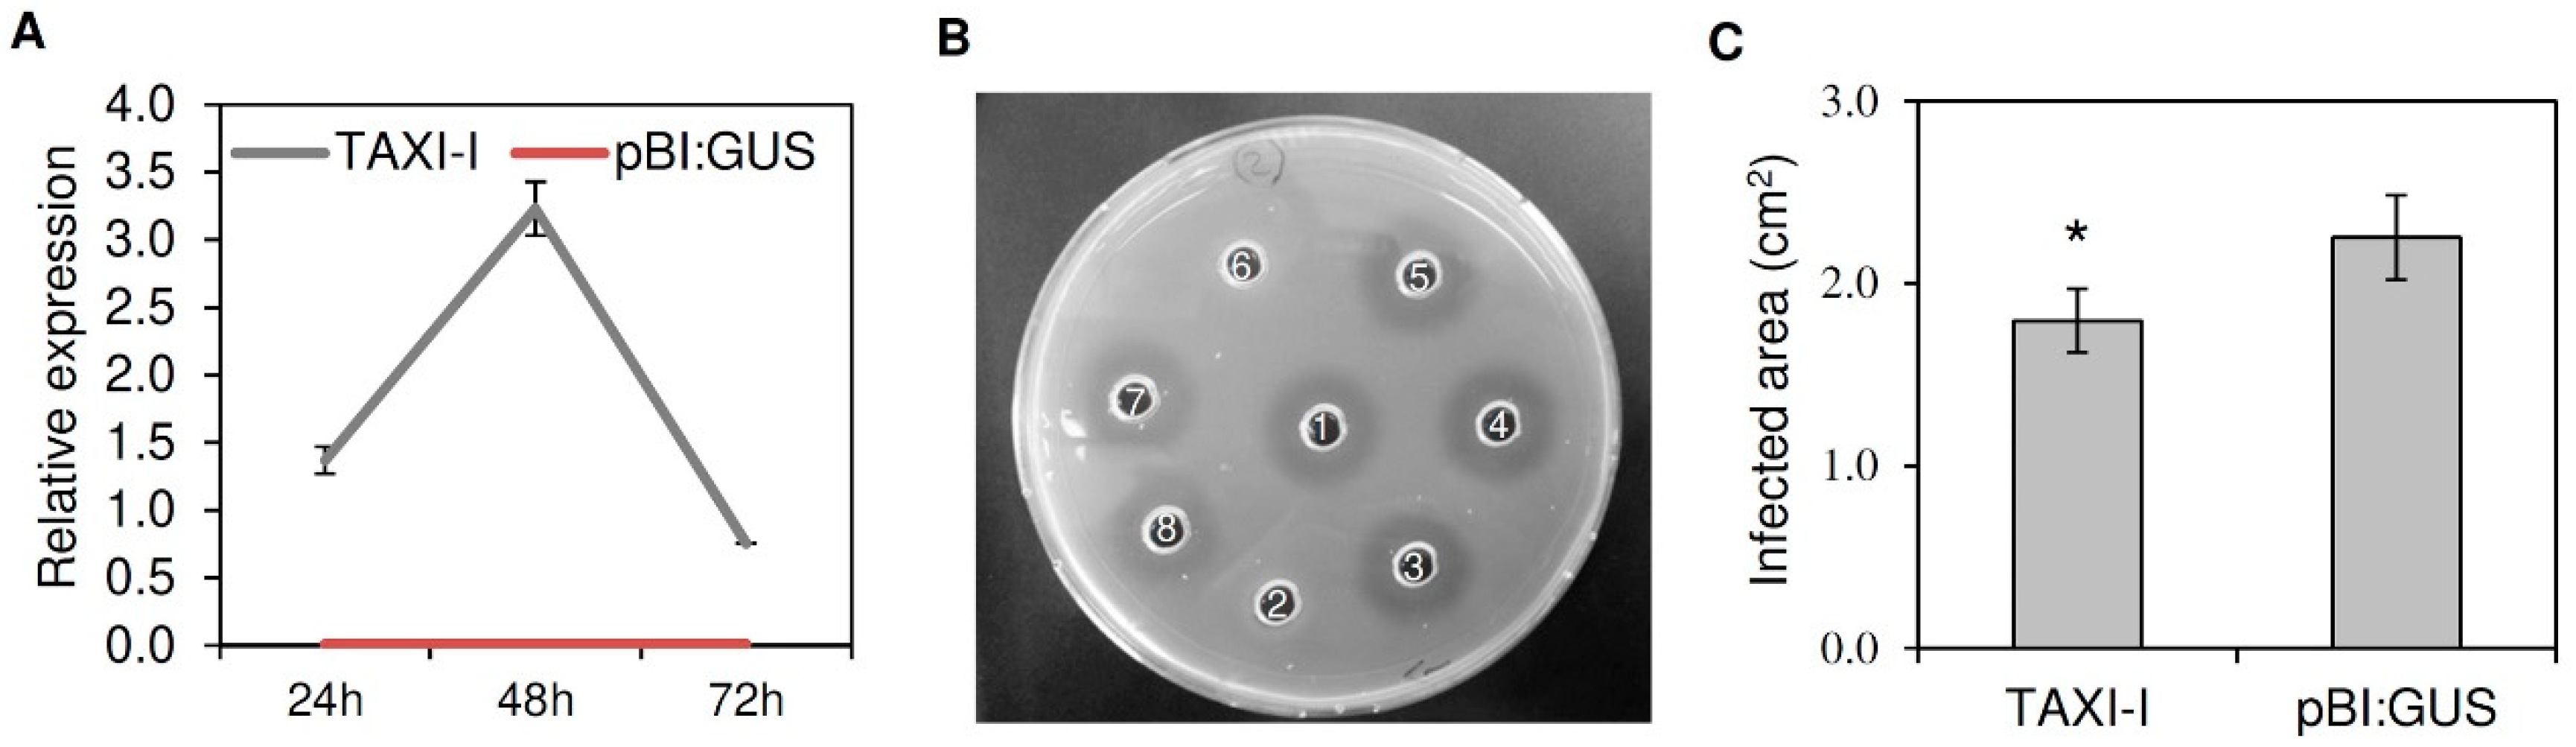
Plants 09 00601 g001 Plants 09 00601 g001

The Xylanase Inhibitor TAXI-I Increases Plant Resistance to Botrytis cinerea by Inhibiting the BcXyn11a Xylanase Necrotizing Activity
Abstract
1. Introduction
2. Results
2.1. Tobacco Plants Transiently Expressing TAXI-I Show Increased Resistance to B. Cinerea
2.2. Production and Characterization of TAXI-I Transgenic Arabidopsis Lines
2.3. TAXI-I Limits B. Cinerea Infection in Planta and Inhibits the Necrotizing Activity of BcXyn11a in a Dose-Dependent Manner
2.4. TAXI-I Does Not Provide Resistance to P. Syringae pv. Maculicola
3. Discussion
4. Materials and Methods
4.1. Cloning, Heterologous Expression and Purification of BcXyn11a
4.2. Production of the TAXI-I Construct
4.3. Tobacco and Arabidopsis Agrobacterium-Mediated Transformation
4.4. RNA Extraction, cDNA Preparation and Gene Expression Analyses
4.5. Plant and Fungal Growth Conditions and Plant Infection Assays
4.6. Extraction and Purification of TAXI-I and Enzymatic Assays
4.7. Necrosis and H2O2 Production in Arabidopsis Leaves
4.8. Statistical Analysis
5. Conclusions
Supplementary Materials
Author Contributions
Funding
Acknowledgments
Conflicts of Interest
References
- Elad, Y.; Pertot, I.; Prado, A.M.C.; Stewart, A. Plant hosts of Botrytis spp. In Botrytis, the Good, the Bad and the Ugly; Elad, Y., Vivier, M., Fillinger, S., Eds.; Springer: New York, NY, USA, 2016; pp. 413–448. [Google Scholar]
- Weiberg, A.; Wang, M.; Lin, F.M.; Zhao, H.; Zhang, Z.; Kaloshian, I.; Huang, H.D.; Jin, H. Fungal small RNAs suppress plant immunity by hijacking host RNA interference pathways. Science 2013, 342, 118–123. [Google Scholar] [CrossRef] [PubMed]
- Pandaranayaka, E.P.; Frenkel, O.; Elad, Y.; Prusky, D.; Harel, A. Network analysis exposes core functions in major lifestyles of fungal and oomycete plant pathogens. BMC Genom. 2019, 20, 1020. [Google Scholar] [CrossRef] [PubMed]
- Veloso, J.; van Kan, J.A.L. Many shades of grey in Botrytis-host plant interactions. Trends Plant Sci. 2018, 23, 613–622. [Google Scholar] [CrossRef] [PubMed]
- Brito, N.; Espino, J.J.; González, C. The endo-β-1,4-xylanase Xyn11A is required for virulence in Botrytis cinerea. Mol. Plant Microbe Interact. 2006, 19, 25–32. [Google Scholar] [CrossRef]
- Noda, J.; Brito, N.; González, C. The Botrytis cinerea xylanase Xyn11A contributes to virulence with its necrotizing activity, not with its catalytic activity. BMC Plant Biol. 2010, 10, 38. [Google Scholar] [CrossRef]
- Cooper, R.M.; Longman, D.; Campbell, A.; Henry, M.; Lees, P.E. Enzymatic adaptation of cereal pathogens to the monocotyledonous primary wall. Physiol. Mol. Plant Pathol. 1988, 32, 33–47. [Google Scholar] [CrossRef]
- Yu, Y.; Xiao, J.; Du, J.; Yang, Y.; Bi, C.; Qing, L. Disruption of the gene encoding endo-β-1,4-xylanase affects the growth and virulence of Sclerotinia sclerotiorum. Front. Microbiol. 2016, 7, 1787. [Google Scholar] [CrossRef]
- Frías, M.; González, M.; González, C.; Brito, N. A 25-residue peptide from Botrytis cinerea xylanase BcXyn11A elicits plant defenses. Front Plant Sci. 2019, 10, 474. [Google Scholar] [CrossRef]
- Debyser, W.; Peumans, W.J.; Van Damme, E.J.M.; Delcour, J.A. Triticum aestivum xylanase inhibitor (TAXI), a new class of enzyme inhibitor affecting breadmaking performance. J. Cereal Sci. 1999, 30, 39–43. [Google Scholar] [CrossRef]
- McLauchlan, W.R.; Garcia-Conesa, M.T.; Williamson, G.; Roza, M.; Ravestein, P.; Maat, J. A novel class of protein from wheat which inhibits xylanases. Biochem. J. 1999, 338, 441–446. [Google Scholar] [CrossRef] [PubMed]
- Fierens, E.; Rombouts, S.; Gebruers, K.; Goesaert, H.; Brijs, K.; Beaugrand, J.; Volckaert, G.; Van Campenhout, S.; Proost, P.; Courtin, C.M.; et al. TLXI, a novel type of xylanase inhibitor from wheat (Triticum aestivum) belonging to the thaumatin family. Biochem. J. 2007, 403, 583–591. [Google Scholar] [CrossRef]
- Dornez, E.; Croes, E.; Gebruers, K.; De Coninck, B.; Cammue, B.P.A.; Delcour, J.A.; Courtin, C.M. Accumulated evidence substantiates a role for three classes of wheat xylanase inhibitors in plant defense. Crit. Rev. Plant Sci. 2010, 29, 244–264. [Google Scholar] [CrossRef]
- Moscetti, I.; Tundo, S.; Janni, M.; Sella, L.; Gazzetti, K.; Tauzin, A.; Giardina, T.; Masci, S.; Favaron, F.; D’Ovidio, R. Constitutive expression of the xylanase inhibitor TAXI-III delays Fusarium Head Blight symptoms in durum wheat transgenic plants. Mol. Plant Microbe Interact. 2013, 26, 1464–1472. [Google Scholar] [CrossRef] [PubMed]
- Hou, C.; Lv, T.; Zhan, Y.; Peng, Y.; Huang, Y.; Jiang, D.; Weng, X. Overexpression of the RIXI xylanase inhibitor improves disease resistance to the fungal pathogen, Magnaporthe oryzae, in rice. Plant Cell Tiss. Org. 2015, 120, 167–177. [Google Scholar] [CrossRef]
- Sun, R.J.; Xu, Y.; Hou, C.X.; Zhan, Y.H.; Liu, M.Q.; Weng, X.Y. Expression and characteristics of rice xylanase inhibitor OsXIP, a member of a new class of antifungal proteins. Biol. Plantarum 2018, 62, 569–578. [Google Scholar] [CrossRef]
- Moscetti, I.; Faoro, F.; Moro, S.; Sabbadin, D.; Sella, L.; Favaron, F.; D’Ovidio, R. The xylanase inhibitor TAXI-III counteracts the necrotic activity of a Fusarium graminearum xylanase in vitro and in durum wheat transgenic plants. Mol. Plant Pathol. 2015, 16, 583–592. [Google Scholar] [CrossRef]
- Tundo, S.; Moscetti, I.; Faoro, F.; Lafond, M.; Giardina, T.; Favaron, F.; Sella, L.; D’Ovidio, R. Fusarium graminearum produces different xylanases causing host cell death that is prevented by the xylanase inhibitors XIP-I and TAXI-III in wheat. Plant Sci. 2015, 240, 161–169. [Google Scholar] [CrossRef]
- Sella, L.; Gazzetti, K.; Faoro, F.; Odorizzi, S.; D’Ovidio, R.; Schäfer, W.; Favaron, F. A Fusarium graminearum xylanase expressed during wheat infection is a necrotizing factor but is not essential for virulence. Plant Physiol. Biochem. 2013, 64, 1–10. [Google Scholar] [CrossRef]
- Sella, L.; Gazzetti, K.; Castiglioni, C.; Schäfer, W.; D’Ovidio, R.; Favaron, F. The Fusarium graminearum Xyr1 transcription factor regulates xylanase expression but is not essential for fungal virulence. Plant Pathol. 2016, 65, 713–722. [Google Scholar] [CrossRef]
- Paccanaro, M.C.; Sella, L.; Castiglioni, C.; Giacomello, F.; Martínez-Rocha, A.L.; D’Ovidio, R.; Schäfer, W.; Favaron, F. Synergistic effect of different plant cell wall-degrading enzymes is important for virulence of Fusarium graminearum. Mol. Plant Microbe Interact. 2017, 30, 886–895. [Google Scholar] [CrossRef]
- Igawa, T.; Ochiai-Fukuda, T.; Takahashi-Ando, N.; Ohsato, S.; Takehico, S.; Yamaguki, I.; Kimura, M. New TAXI-type xylanase inhibitor genes are inducible by pathogens and wounding in hexaploid wheat. Plant Cell Physiol. 2004, 45, 1347–1360. [Google Scholar] [CrossRef] [PubMed]
- Fierens, K.; Brijs, K.; Courtin, C.M.; Gebruers, K.; Goesaert, H.; Raedschelders, G.; Robben, J.; Van Campenhout, S.; Volckaert, G.; Delcour, J.A. Molecular identification of wheat endoxylanase inhibitor TAXI-I, member of a new class of plant proteins. FEBS Lett. 2003, 540, 259–263. [Google Scholar] [CrossRef]
- Gebruers, K.; Debyser, W.; Goesaert, H.; Proost, P.; Van Damme, J.; Delcour, J.A. Triticum aestivum L. endoxylanase inhibitor (TAXI) consists of two inhibitors, TAXI I and TAXI II, with different specificities. Biochem. J. 2001, 353, 239–244. [Google Scholar] [CrossRef] [PubMed]
- Collins, T.; Gerday, C.; Feller, G. Xylanases, xylanase families and extremophilic xylanases. FEMS Microbiol. Rev. 2005, 29, 3–23. [Google Scholar] [CrossRef]
- Brutus, A.; Reca, I.B.; Herga, S.; Mattei, B.; Puigserver, A.; Chaix, J.C.; Juge, N.; Bellincampi, D.; Giardina, T. A family 11 xylanase from the pathogen Botrytis cinerea is inhibited by plant endoxylanase inhibitors XIP-I and TAXI-I. Biochem. Biophys. Res. Commun. 2005, 337, 160–166. [Google Scholar] [CrossRef]
- Rudolph, K.W.E. Pseudomonas syringae pathovars. In Pathogenesis and Host Specificity in Plant Diseases; Singh, R.P.K., Kohmoto, K., Eds.; Elsevier Science: Amsterdam, The Netherlands, 1995; Volume 1, pp. 47–138. [Google Scholar]
- Favaron, F.; Sella, L.; D’Ovidio, R. Relationships Among Endo-Polygalacturonase, Oxalate, pH, and Plant Polygalacturonase-Inhibiting Protein (PGIP) in the Interaction Between Sclerotinia sclerotiorum and Soybean. Mol. Plant Microbe Interact. 2004, 17, 1402–1409. [Google Scholar] [CrossRef]
- Zuppini, A.; Navazio, L.; Sella, L.; Castiglioni, C.; Favaron, F.; Mariani, P. An endopolygalacturonase from Sclerotinia sclerotiorum induces calcium-mediated signalling and programmed cell death in soybean cells. Mol. Plant Microbe Interact. 2005, 18, 849–855. [Google Scholar] [CrossRef]
- González-Fernández, R.; Valero-Galván, J.; Gómez-Gálvez, F.J.; Jorrín-Novo, J.V. Unraveling the in vitro secretome of the phytopathogen Botrytis cinerea to understand the interaction with its hosts. Front. Plant Sci. 2015, 6, 839. [Google Scholar] [CrossRef]
- Li, H.; Chen, Y.; Zhang, Z.Q.; Li, B.Q.; Qin, G.Z.; Tian, S.P. Pathogenic mechanisms and control strategies of Botrytis cinerea causing post-harvest decay in fruits and vegetables. Food Qual. Saf. 2018, 3, 111–119. [Google Scholar]
- Choquer, M.; Fournier, E.; Kunz, C.; Levis, C.; Pradier, J.M.; Simon, A.; Viaud, M. Botrytis cinerea virulence factors: New insights into a necrotrophic and polyphageous pathogen. FEMS Microbiol. Lett. 2007, 277, 1–10. [Google Scholar] [CrossRef]
- Govrin, E.M.; Levine, A. The hypersensitive response facilitates plant infection by the necrotrophic pathogen Botrytis cinerea. Curr. Biol. 2000, 10, 751–757. [Google Scholar] [CrossRef]
- Van Kan, J.A. Licensed to kill: The lifestyle of a necrotrophic plant pathogen. Trends Plant Sci. 2006, 11, 247–253. [Google Scholar] [CrossRef] [PubMed]
- Williamson, B.; Tudzynski, B.; Tudzynski, P.; Van Kan, J.A.L. Botrytis cinerea: The cause of grey mould disease. Mol. Plant Pathol. 2007, 8, 561–580. [Google Scholar] [CrossRef] [PubMed]
- Ten Have, A.; Mulder, W.; Visser, J.; van Kan, J.A.L. The endopolygalacturonase gene Bcpg1 is required for full virulence of Botrytis cinerea. Mol. Plant Microbe Interact. 1998, 11, 1009–1016. [Google Scholar] [CrossRef] [PubMed]
- Kars, I.; Krooshof, G.H.; Wagemakers, L.; Joosten, R.; Benen, J.A.E.; van Kan, J.A.L. Necrotizing activity of five Botrytis cinerea endopolygalacturonases produced in Pichia pastoris. Plant J. 2005, 43, 213–225. [Google Scholar] [CrossRef]
- Benedetti, M.; Leggio, C.; Federici, L.; De Lorenzo, G.; Pavel, N.V.; Cervone, F. Structural resolution of the complex between a fungal polygalacturonase and a plant polygalacturonase-inhibiting protein by small-angle X-ray scattering. Plant Physiol. 2011, 157, 599–607. [Google Scholar] [CrossRef][Green Version]
- Ron, M.; Avni, A. The receptor for the fungal elicitor ethylene-inducing xylanase is a member of a resistance-like gene family in tomato. Plant Cell 2004, 16, 1604–1615. [Google Scholar] [CrossRef]
- Kalunke, R.M.; Moscetti, I.; Tundo, S.; D’Ovidio, R. An improved and simplified radial gel diffusion assay for the detection of xylanase activity. Bio Protoc. 2016, 6. [Google Scholar] [CrossRef]
- Bradford, M.M. A rapid and sensitive method for the quantitation of microgram quantities of protein utilizing the principle of protein-dye binding. Anal. Biochem. 1976, 72, 248–254. [Google Scholar] [CrossRef]
- Bertacco, E.; Millioni, R.; Arrigoni, G.; Faggin, E.; Iop, L.; Puato, M.; Pinna, L.A.; Tessari, P.; Pauletto, P.; Rattazzi, M. Proteomic analysis of clonal interstitial aortic valve cells acquiring a pro-calcific profile. J. Proteome Res. 2010, 9, 5913–5921. [Google Scholar] [CrossRef]
- Mozo, T.; Hooykaas, P.J. Electroporation of megaplasmids into Agrobacterium. Plant Mol. Biol. 1991, 16, 917–918. [Google Scholar] [CrossRef] [PubMed]
- Voinnet, O.; Rivas, S.; Mestre, P.; Baulcombe, D. An enhanced transient expression system in plants based on suppression of gene silencing by the p19 protein of tomato bushy stunt virus. Plant J. 2003, 33, 949–956. [Google Scholar] [CrossRef] [PubMed]
- Ghedira, R.; De Buck, S.; Nolf, J.; Depicker, A. The efficiency of Arabidopsis thaliana floral dip transformation is determined not only by the Agrobacterium strain used but also by the physiology and the ecotype of the dipped plant. Mol. Plant Microbe Interact. 2013, 26, 823–832. [Google Scholar] [CrossRef] [PubMed]
- Morcx, S.; Kunz, C.; Choquer, M.; Assie, S.; Blondet, E.; Simond-Côte, E.; Gajek, K.; Chapeland-Leclerc, F.; Expert, D.; Soulie, M.C. Disruption of Bcchs4, Bcchs6 or Bcchs7 chitin synthase genes in Botrytis cinerea and the essential role of class VI chitin synthase (Bcchs6). Fungal Genet. Biol. 2013, 52, 1–8. [Google Scholar] [CrossRef] [PubMed]
- Miller, G.L. Use of dinitrosalicylic acid reagent for determination of reducing sugars. Anal. Chem. 1959, 31, 426–428. [Google Scholar] [CrossRef]
- Bailey, M.J.; Biely, P.; Poutanen, K. Interlaboratory testing of methods for assay of xylanase activity. J. Biotechnol. 1992, 23, 257–270. [Google Scholar] [CrossRef]
- Lionetti, V.; Raiola, A.; Camardella, L.; Giovane, A.; Obel, N.; Pauly, M.; Favaron, F.; Cervone, F.; Bellincampi, D. Overexpression of pectin methylesterase inhibitors in Arabidopsis restricts fungal infection by Botrytis cinerea. Plant Physiol. 2007, 143, 1871–1880. [Google Scholar] [CrossRef]
- Takahama, U. Redox state of ascorbic acid in the apoplast of stems of Kalanchoë daigremontiana. Physiol. Plant. 1993, 89, 791–798. [Google Scholar] [CrossRef]
- Quarantin, A.; Castiglioni, C.; Schäfer, W.; Favaron, F.; Sella, L. The Fusarium graminearum cerato-platanins loosen cellulose substrates enhancing fungal cellulase activity as expansin-like proteins. Plant Physiol. Biochem. 2019, 139, 229–238. [Google Scholar] [CrossRef]
- AbuQamar, S.F.; Moustafa, K.; Tran, L.P. ‘Omics’ and plant responses to Botrytis cinerea. Front. Plant Sci. 2016, 7, 1658. [Google Scholar] [CrossRef]

© 2020 by the authors. Licensee MDPI, Basel, Switzerland. This article is an open access article distributed under the terms and conditions of the Creative Commons Attribution (CC BY) license (http://creativecommons.org/licenses/by/4.0/).
Share and Cite
Tundo, S.; Paccanaro, M.C.; Elmaghraby, I.; Moscetti, I.; D’Ovidio, R.; Favaron, F.; Sella, L. The Xylanase Inhibitor TAXI-I Increases Plant Resistance to Botrytis cinerea by Inhibiting the BcXyn11a Xylanase Necrotizing Activity. Plants 2020, 9, 601. https://doi.org/10.3390/plants9050601
Tundo S, Paccanaro MC, Elmaghraby I, Moscetti I, D’Ovidio R, Favaron F, Sella L. The Xylanase Inhibitor TAXI-I Increases Plant Resistance to Botrytis cinerea by Inhibiting the BcXyn11a Xylanase Necrotizing Activity. Plants. 2020; 9(5):601. https://doi.org/10.3390/plants9050601
Chicago/Turabian StyleTundo, Silvio, Maria Chiara Paccanaro, Ibrahim Elmaghraby, Ilaria Moscetti, Renato D’Ovidio, Francesco Favaron, and Luca Sella. 2020. "The Xylanase Inhibitor TAXI-I Increases Plant Resistance to Botrytis cinerea by Inhibiting the BcXyn11a Xylanase Necrotizing Activity" Plants 9, no. 5: 601. https://doi.org/10.3390/plants9050601
APA StyleTundo, S., Paccanaro, M. C., Elmaghraby, I., Moscetti, I., D’Ovidio, R., Favaron, F., & Sella, L. (2020). The Xylanase Inhibitor TAXI-I Increases Plant Resistance to Botrytis cinerea by Inhibiting the BcXyn11a Xylanase Necrotizing Activity. Plants, 9(5), 601. https://doi.org/10.3390/plants9050601

